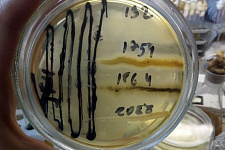
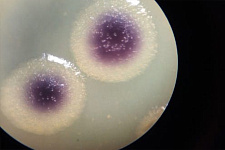

Биотехнологи НИУ «БелГУ» из прибрежной зоны белгородской реки Везелка выделили бактерию, образующую пигмент сине-фиолетового цвета
Аборигенная бактерия может быть использована при создании биопрепаратов с антибактериальными, антимикозными и противовирусными свойствами
Исследования по выделению и изучению нового штамма, отвечающие приоритетам программы НОЦ мирового уровня «Инновационные решения в АПК», проведены студентами и сотрудниками института фармации, химии и биологии НИУ «БелГУ» совместно с учеными института биохимии и физиологии микроорганизмов ФИЦ ПНЦБИ РАН при поддержке Центра коллективного пользования UNIQEM Collection.
По словам директора Регионального микробиологического центра НИУ «БелГУ», доктора биологических наук Инны Соляниковой, пигмент, образованный новым штаммом бактерии, на основании химических и спектрофотометрических исследований неочищенного этанольного экстракта идентифицирован как виолацеин. Он обладает биологической активностью и значительным фармакологическим потенциалом, например, виолацеину присуща противовирусная активность в отношении вируса простого герпеса.
Бактерия очень красивая, со временем у клеток развивается насыщенный фиолетовый цвет. Клетки штамма JF4 растут в диапазоне температур 8–28°С с оптимумом при 20–25°С, что, в целом, может облегчить применение биопрепаратов на основе этого штамма в естественных условиях, так как больше соответствует температуре воды и верхним слоям почвы.
Обнадеживающим признаком, с точки зрения потенциального использования в биотехнологиях, является чувствительность данного штамма к большинству из проверенных 38 коммерческих антибиотиков различных классов.
Полученные на первом этапе исследования результаты говорят о потенциальной биотехнологической значимости нового штамма, а именно перспективах его использования при создании биопрепаратов, обладающих антибактериальными, антимикозными, противовирусными и т.д. свойствами. В рамках дальнейших исследований аборигенной пигментообразующей бактерии и продуктов ее метаболизма будет изучена и дана оценка ее конкретного биотехнологического применения.
- Студенты, обучающиеся на кафедре биотехнологии и микробиологии, были вовлечены в увлекательный процесс научных исследований, получив хороший опыт в подобного рода деятельности: формулирование цели, определение задач исследования, методов их достижения, проведение лабораторных экспериментов, - оказавшихся еще и очень результативными. Написанная по полученным результатам статья была опубликована в научном журнале, индексируемом такими базами данных, как Web of Science и Scopus – рассказала Инна Петровна.
Для справки: Бактериальные клетки являются продуцентами огромного количества биологически-активных соединений, среди которых витамины, аминокислоты, антибиотики, ферменты. Сегодня оценено биотехнологическое значение еще одной группы вторичных метаболитов бактерий, – пигментов. Роль пигментов для микроорганизмов может заключаться в участии в процессах дыхания, защите от ультрафиолетового излучения. Кроме того, некоторые микроорганизмы синтезируют пигменты, обладающие антибактериальными или антимикозными свойствами.
15.03.2021
| << Назад к списку | | Просмотров: 2283 |
Войти, чтобы оставить комментарий.